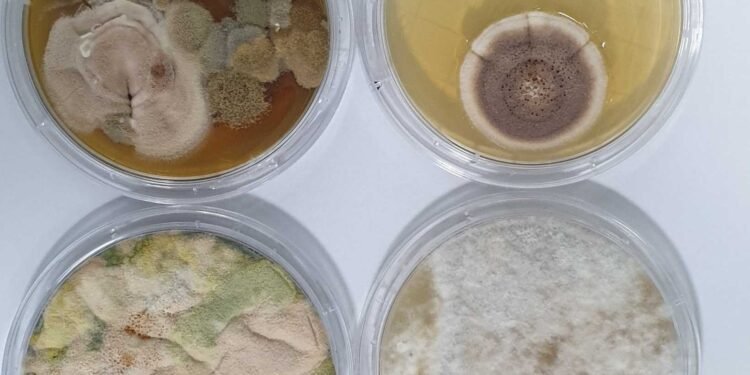
The Pros and Cons of DIY Mold Testing: A Homeowner's Guide

DIY mold testing is becoming increasingly popular among homeowners who want to identify mold growth and take action to prevent it from spreading. While DIY testing kits are more affordable and convenient than hiring a professional mold inspector, they may not be as accurate or precise. It’s important for homeowners to understand the pros and cons of DIY mold testing before deciding whether to use them.

Mold accumulation is a common problem in many homes, leading to various health issues if left untreated. It can also cause structural damage and decrease the value of the property. Testing for and addressing mold buildup regularly and as soon as possible is crucial. A certified mold inspection is crucial to ensure the accurate detection of mold and effective remediation. However, some homeowners may opt for DIY mold testing kits as a more affordable and convenient option.
Key Takeaways
- DIY mold testing kits offer a cost-effective and convenient option for homeowners who want to identify mold growth.
- Professional inspectors bring expertise, specialized equipment, and the ability to assess hidden areas, providing more accurate and precise results.
- Homeowners should carefully consider the pros and cons of DIY mold testing before deciding whether to use them.
Understanding Mold and Its Impacts on Health

Mold is a type of fungus that can grow indoors and outdoors, and it thrives in moist and warm environments. While mold plays an essential role in breaking down organic matter, it can cause health issues when it grows inside a home. Mold can produce allergens, irritants, and mycotoxins that can cause a range of health problems, from minor allergic reactions to severe respiratory issues.
Types of Mold and Health Risks
There are many types of mold, and each type can have different health risks. Some common types of mold found in homes include Aspergillus, Cladosporium, Penicillium, and Stachybotrys chartarum. While not all mold species are toxic, some molds can produce mycotoxins that can cause severe health problems. Exposure to mold can cause allergic reactions, respiratory problems, and skin irritation.
Signs and Symptoms of Mold Exposure
Exposure to mold can cause a range of symptoms, from mild to severe. Some common symptoms of mold exposure include coughing, sneezing, wheezing, runny nose, itchy eyes, and skin irritation. People with compromised immune systems, such as the elderly, young children, and those with chronic respiratory problems, are more susceptible to the harmful effects of mold exposure. If you suspect that you have mold in your home, it’s essential to take action to address the problem promptly.
In conclusion, understanding the health risks associated with mold exposure is crucial for every homeowner. While some types of mold are harmless, others can cause severe health problems. By knowing the signs and symptoms of mold exposure, homeowners can take action to protect their health and the health of their families.
DIY Mold Testing Explained
What Is DIY Mold Testing?
DIY mold testing is a process of collecting and analyzing samples of mold from a home or building. It is a way for homeowners to determine if there is a mold problem in their home without hiring a professional. DIY mold testing can be done using a mold testing kit that is available in the market. These kits include all the necessary tools and instructions needed to collect samples of mold from various areas of a home.
Components of a Mold Testing Kit
A mold testing kit usually contains the following components:
- Swabs for surface testing: These are used to collect samples from surfaces such as walls, ceilings, and floors.
- Petri dishes for air testing: These are used to collect samples from the air.
- Gloves and masks: These are used to protect the person collecting the samples from exposure to mold.
- Instructions: These provide step-by-step guidance on how to collect samples and how to send them to a lab for analysis.
Mold testing kits can be purchased online or at home improvement stores. They are generally affordable and easy to use, making them a popular option for homeowners who are concerned about mold in their homes.
However, it is important to note that DIY mold testing may not always be accurate. The results can be affected by factors such as the skill level of the person collecting the samples, the type of mold present, and the conditions in the home. In some cases, it may be necessary to hire a professional mold inspector to get an accurate assessment of the mold problem in a home.
Overall, DIY mold testing can be a useful tool for homeowners who want to determine if there is a mold problem in their home. However, it is important to use caution and to understand the limitations of DIY testing. If a mold problem is suspected, it may be best to consult with a professional to ensure that the problem is properly identified and addressed.
Pros of DIY Mold Testing

Mold is a common problem in many homes, and it can pose a health risk to the occupants. DIY mold testing is an affordable and convenient way to detect mold in your home. Here are some of the pros of DIY mold testing:
Cost-Effectiveness and Convenience
One of the main advantages of DIY mold testing is that it is cost-effective. Homeowners can purchase DIY mold testing kits at a fraction of the cost of professional mold testing. These kits are widely available at hardware stores, home improvement centers, and online retailers.
DIY mold testing is also convenient. Homeowners can perform the test at their own pace and on their own schedule. They do not need to wait for a professional to come and perform the test, which can save time and hassle.
Immediate Results and Accessibility
Another benefit of DIY mold testing is that it provides immediate results. Homeowners can get the results of their mold test within a few days of sending the samples to the lab. This can help them take immediate action to address any mold problems in their home.
DIY mold testing is also accessible. Homeowners can perform the test themselves without any specialized training or equipment. The testing kits come with easy-to-follow instructions, making it simple for anyone to perform the test.
In conclusion, DIY mold testing has several pros, including cost-effectiveness, convenience, immediate results, and accessibility. However, it is important to note that DIY mold testing may not be as accurate or comprehensive as professional mold testing. Homeowners should carefully consider their specific needs and budget before deciding whether to perform a DIY mold test or hire a professional.
Cons of DIY Mold Testing
While DIY mold testing kits may seem like a cost-effective solution, they do have some drawbacks. Here are some of the cons of DIY mold testing that every homeowner should be aware of:
Accuracy Concerns and Limitations
DIY mold testing kits have limitations when it comes to accuracy. These kits can only test for mold in the areas where the homeowner decides to take samples. This means that if there is mold in an area that the homeowner did not test, it may go undetected. Additionally, DIY mold testing kits may not be able to identify all types of mold, leading to inaccurate results.
Risk of False Positives and Negatives
One of the biggest concerns with DIY mold testing is the risk of false positives and false negatives. False positives occur when the test results indicate the presence of mold when there is none. False negatives, on the other hand, occur when the test results indicate no mold is present when it actually is. These inaccuracies can lead to unnecessary expenses or health risks if mold is not detected or if remediation is carried out unnecessarily.
To ensure accurate results, it is recommended that homeowners hire a professional mold inspector to conduct a thorough inspection. Professionals have the necessary training and experience to identify the presence of mold, assess its extent, and determine the best course of action.
Professional Mold Testing as an Alternative

While DIY mold testing kits are easily accessible and affordable, they may not always provide the most accurate results. In some cases, professional mold testing may be a better alternative for homeowners who want to ensure the safety of their homes and families.
Benefits of Expert Assessment
One of the primary benefits of professional mold testing is the expertise that comes with it. Professional inspectors have the training and experience needed to identify different types of mold and understand the potential health risks associated with each one. They can also provide guidance on how to remedy any mold problems that are identified.
Another advantage of professional mold testing is the use of advanced testing methods. Experts use specialized equipment and techniques to detect mold that may not be visible to the naked eye. This can help ensure that all mold is identified and properly addressed.
Understanding the Costs and Process
While professional mold testing may be more expensive than DIY kits, it is important to consider the potential costs of not identifying and addressing mold problems. Mold can cause serious health problems and damage to the home, which can be costly to repair.
The cost of professional mold testing varies depending on the size of the home and the extent of the testing needed. Homeowners can expect to pay anywhere from a few hundred to several thousand dollars for a professional mold inspection.
The process of professional mold testing typically involves a visual inspection of the home, air and surface sampling, and laboratory analysis of the samples collected. The inspector will then provide a detailed report of their findings and recommendations for remediation if necessary.
Overall, while DIY mold testing kits may be a convenient and cost-effective option, professional mold testing may be a better alternative for homeowners who want to ensure the accuracy of their results and the safety of their homes and families.
Interpreting Mold Test Results
Mold testing is an important step in identifying and addressing mold problems in a home. Once the test is complete, the homeowner will receive the results, which can be difficult to understand without some knowledge of the process. This section will explain how to read and understand mold test outcomes and when to seek professional advice.
Reading and Understanding Test Outcomes
Mold test results will typically include information on the type and concentration of mold present in the sample. The lab may also provide recommendations for how to address the mold problem. It is important to note that not all mold is harmful, and some types of mold are found in nearly every home.
If the test results show a positive presence of mold, the homeowner should take action to address the issue. This may include cleaning the affected area or seeking professional help. The severity of the problem will depend on the concentration of mold present and the health symptoms it may be causing.
When interpreting mold test results, it is important to understand that the results are only a snapshot of the mold situation in the home. Mold spores are constantly in the air, and the concentration can fluctuate depending on factors such as humidity and temperature. Therefore, it is important to not rely solely on the test results and to continue to monitor the home for signs of mold growth.
When to Seek Professional Advice
While DIY mold testing can be helpful in identifying a potential mold problem, it is important to know when to seek professional advice. If the test results show a high concentration of mold or if the homeowner is experiencing health symptoms such as coughing or wheezing, it is recommended to seek the help of a professional mold inspector.
A professional mold inspector will be able to provide a more detailed analysis of the mold situation in the home and offer recommendations for how to address the issue. They will also be able to identify any underlying causes of the mold growth, such as water damage or poor ventilation.
In conclusion, interpreting mold test results can be challenging, but it is an important step in addressing mold problems in the home. Homeowners should be aware of the limitations of DIY testing and know when to seek professional advice. By taking action to address mold problems, homeowners can protect their health and the health of their families.
Remediation and Prevention Strategies

Steps for Treating Identified Mold Problems
If a homeowner has identified a mold problem, it is important to take steps to treat it promptly. The extent of mold growth will determine whether a DIY approach is appropriate or if professional mold remediation is necessary. In cases of extensive mold growth or water damage, it is recommended to seek the assistance of a professional. Attempting to remove large amounts of mold without proper training and equipment can be dangerous and result in costly repairs.
For smaller mold problems, homeowners can use DIY mold remediation techniques. It is important to wear protective gear, such as gloves and a mask, and to follow the instructions on mold removal products carefully. In addition, it is important to identify and address the source of the moisture that caused the mold growth. Simply removing the mold without addressing the underlying issue will likely result in future mold growth.
Preventing Future Mold Growth
Preventing future mold growth is essential to maintaining a mold-free home. Homeowners can take several steps to prevent mold growth, including:
- Addressing water damage promptly: Any water damage, such as from a leaky roof or a burst pipe, should be addressed as soon as possible to prevent mold growth.
- Maintaining proper ventilation: Proper ventilation helps to keep the air circulating and prevent damp and humid conditions that can lead to mold growth.
- Maintaining proper humidity levels: Keeping the humidity level in the home below 60% can help prevent mold growth.
- Regularly cleaning and inspecting the home: Regularly cleaning and inspecting the home, especially in areas prone to moisture, can help prevent mold growth.
By taking steps to address water damage promptly, maintain proper ventilation and humidity levels, and regularly clean and inspect the home, homeowners can prevent future mold growth and avoid costly mold remediation.
Considerations Before Buying or Selling a Home
When buying or selling a home, it is important to consider the presence of mold. Mold can cause serious health problems and structural damage. Therefore, it is essential to have a mold inspection before buying or selling a home.
The Role of Mold Inspections in Real Estate Transactions
Mold inspections play a crucial role in real estate transactions. A professional mold inspection can help identify any mold problems in the home. This information can be used to negotiate the price of the home or to determine if the home is worth buying at all.
If mold is found during the inspection, it is important to have it remediated by a professional. It is not recommended to attempt to remove mold on your own, as this can cause the mold to spread and create further problems.
It is also important to note that some insurance companies may not cover mold damage. Therefore, it is important to discuss mold coverage with your insurance agent before buying or selling a home.
In summary, mold can be a serious problem when buying or selling a home. It is important to have a professional mold inspection before making any decisions. This can help ensure that the home is safe and free of any mold problems.
Frequently Asked Questions
How reliable are home mold test kits compared to professional assessments?
Home mold test kits can provide accurate results if used correctly. However, the accuracy of the results can vary depending on the quality of the kit and the user’s ability to follow the instructions. Professional mold assessments are generally more reliable because they use specialized equipment and trained professionals to identify and test for mold.
What should I expect to see in normal mold test kit results?
Normal mold test kit results should show the presence or absence of mold spores in the tested area. The results may also include information about the type of mold present and the concentration of spores in the air. Homeowners should compare their results to the acceptable levels of mold spores as determined by the Environmental Protection Agency (EPA).
Can I accurately test for mold within my home’s walls on my own?
It is difficult to accurately test for mold within your home’s walls on your own. Mold can grow behind walls, making it difficult to detect without specialized equipment. Homeowners should consider hiring a professional mold inspector to test for mold within their walls.
What are the limitations of DIY mold testing compared to hiring a professional service?
DIY mold testing has several limitations compared to hiring a professional service. Homeowners may not have access to specialized equipment or the knowledge to identify all types of mold. Professional mold inspectors can also provide a more comprehensive assessment of the mold problem and recommend appropriate remediation measures.
How can homeowners effectively test the air for mold presence?
Homeowners can effectively test the air for mold presence by using an air sampling pump and a spore trap. The pump collects air samples, which are then analyzed for the presence of mold spores. Homeowners should follow the instructions carefully and send the samples to a reputable laboratory for analysis.
What methods do professionals use to ensure the accuracy of a mold inspection?
Professionals use several methods to ensure the accuracy of a mold inspection. They may use specialized equipment such as moisture meters, thermal imaging cameras, and borescopes to detect moisture and mold growth. They may also take air and surface samples to test for mold presence and identify the type of mold present. Finally, they may provide recommendations for remediation measures based on their findings.